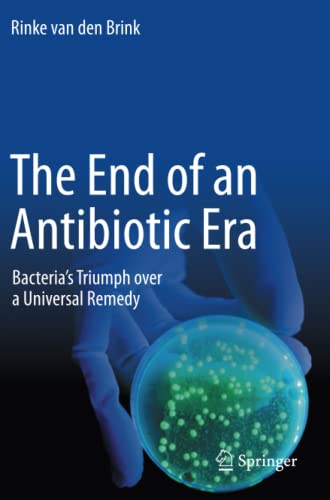

The End of an Antibiotic Era: Bacteria’s Triumph over a Universal Remedy (Original PDF from Publisher)
By Rinke van den Brink
In this monograph, journalist Rinke van den Brink takes a closer look at the limitations and risks of today’s antibiotic use. Though all developed societies have grown accustomed to successfully treating bacterial infections with these wonder drugs, the author focuses on the increasing number of antibiotic-resistant infections. By examining recent mass outbreaks, readers will gain a better understanding of the global impact of antimicrobial resistance – one of the most serious public health threats today.
Following this somewhat disquieting review of the status quo, interviews with a number of specialists provide an outlook on possible solutions. In a world that is more connected than ever, partnerships between different healthcare systems are becoming all the more important. Rinke van den Brink uses the example of a border-spanning collaboration between the Netherlands and Germany to demonstrate how effective lines of communication can be established.
The book offers a wealth of useful background information for healthcare personnel. Not only does it share insights into the functional microbe-antibiotic relationship; it also discusses how clinics can effectively address outbreaks, helping readers to learn from past experiences and develop effective new strategies.
Product Details
- Publisher : Springer; 1st ed. 2021 edition (May 14, 2021)
- Language : English
- Paperback : 344 pages
- ISBN-10 : 3030707229
- ISBN-13 : 978-3030707224
- ISBN-13 : 9783030707224
- eText ISBN: 9783030707231